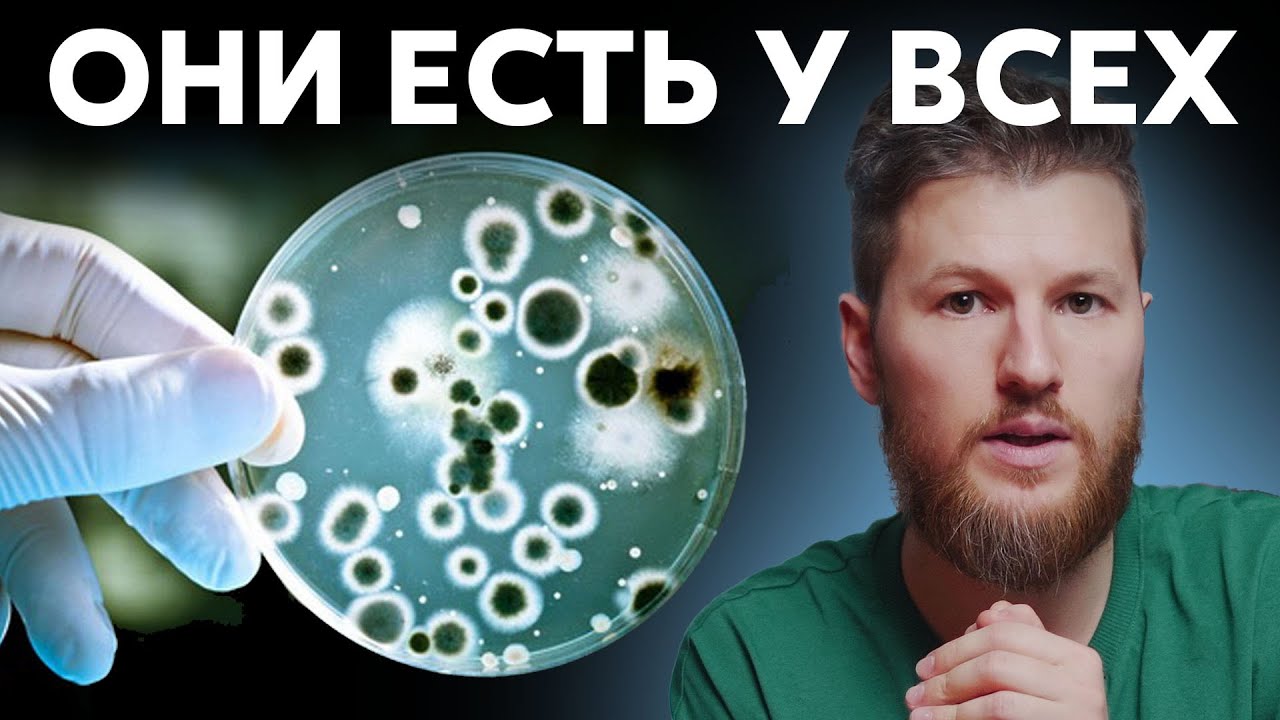

Грибок является неприятным заболеванием, но еще больший дискомфорт этот недуг приносит тогда, когда возникает в области заднего прохода. В медицине такое заболевание называется анальным кандидозом. По симптомам своего проявления грибок на попе может напоминать гельминтоз. Из-за этого человек с существенным опозданием приступает к эффективному лечению, что усложняет процесс выздоровления. Чтобы этого избежать, необходимо знать все признаки грибковой инфекции, протекающей в области заднего прохода.
Этиологические факторы, пути заражения грибком заднего прохода
Грибок, появившийся в области анального отверстия, вызывает такой патогенный микроорганизм, как Candida. При этом нужно учитывать, что кандида в небольшом количестве содержится на кожном и слизистом покрове любого здорового человека. Патогенный процесс начинает развиваться тогда, когда этот микроорганизм начинает усиленно размножаться.
Учитывая такие особенности, инфекция грибкового характера может долгое время находиться в пассивном состоянии. Но как только иммунная система ослабевает, грибы увеличивают свое количество, возникает кандидоз заднего прохода. С таким заболеванием могут столкнуться и женщины, и мужчины. Но наиболее уязвимыми становятся люди пожилого возраста, а также маленькие дети.
Провоцирующими факторами к образованию такого недуга являются анальная молочница кожи и кандидоз, который сначала развивается в желудочном и кишечном тракте. Молочница первоначально также имеет грибковую природу. Сначала она поражает слизистую кишечную стенку, а потом проникает и в саму прямую кишку. Кишечный кандидоз появляется на фоне дисбактериоза, туберкулеза, авитаминоза, сахарного диабета, болезни суставов.
Очень часто развитию такого вида грибка способствует кандидозный дерматит. Патогенные микроорганизмы поражают кожные покровы и слизистую заднего прохода. В группу риска попадают люди, имеющие лишний вес, те, кто склонен к нетрадиционным сексуальным контактам, и женщины, сталкивающиеся с влагалищным кандидозом.
Сопутствующими факторами к развитию недуга становятся:
- присутствие паразитов в организме человека,
- ношение узкой одежды и тесного нательного белья, особенно если оно пошито из синтетической ткани,
- запоры и диареи регулярного характера,
- игнорирование правил личной гигиены.
Все это может способствовать развитию неприятного и очень дискомфортного заболевания.
Врачи отмечают, что анальный кандидоз является распространенной проблемой, особенно среди людей с ослабленным иммунитетом. Для эффективного лечения важно установить точный диагноз, так как симптомы могут перекрываться с другими заболеваниями. Специалисты рекомендуют использовать противогрибковые препараты, такие как кремы или таблетки, которые помогают устранить инфекцию. Параллельно с лечением необходимо соблюдать правила личной гигиены и избегать раздражающих факторов, таких как синтетическое белье и агрессивные моющие средства. Профилактика включает в себя поддержание нормального уровня микрофлоры кишечника, что достигается правильным питанием и приемом пробиотиков. Врачи подчеркивают, что регулярные медицинские осмотры и консультации помогут предотвратить рецидивы и сохранить здоровье.

Факторы риска, симптомы и признаки анального грибка
Грибок на анусе требует незамедлительного лечения, если человек не желает сталкиваться с осложнениями и не хочет больше терпеть неприятную симптоматику. Поэтому так важно, вовремя определить развитие недуга, основываясь на его признаках.
В первую очередь, грибок заднего прохода проявляется усугублением заболевания, на фоне которого он появился.
Затем начинают появляться и другие признаки:
- ощутимые болезненные спазмы в области живота,
- повышенное газообразование, которое становится частым явлением,
- воспаление слизистой оболочки кишечника,
- присутствие молочницы в области половых органов и в ротовой полости,
- небольшое присутствие крови в каловых массах,
- жжение и зуд вблизи ануса,
- наличие паразитов внутри организма,
- герпес заднего прохода.
При этом взрослые люди могут сталкиваться с такими осложнениями, как ректальные кровотечения и развитие сепсиса. Кандидоз имеет свойство быстро распространяться на здоровые органы, затрагивая поджелудочную железу и печень. На фоне этого может возникать язвенная болезнь двенадцатиперстной кишки.
Для постановки точного диагноза человеку приходится проходить внешний осмотр у врача. В этом случае в области ануса обнаруживаются выделения белого цвета.
Проявление грибка заднего прохода у детей
Крайне важно вовремя обнаружить такой недуг у ребенка. Если лечение будет начато с опозданием, могут произойти нарушения, связанные с развитием детского организма. Это может быть остановка роста или сильное снижение веса.
В большинстве случаев кандидоз передается ребенку от матери при рождении либо в период грудного вскармливания. Происходит это, если женщина болела молочницей. Перед родами она проходит специальную обработку, но при этом само заболевание до конца не вылечивается. В итоге, малыш еще до своего рождения становится носителем патогенного грибка в увеличенном количестве.
Определить наличие грибка анального отверстия у совсем маленького ребенка сложно, так как он не может сказать, где у него чешется. Однако заподозрить такой недуг можно, если обратить внимание на поведение ребенка. При анальном кандидозе он постоянно плачет и капризничает. У него нарушается стул, возникают частые поносы, которые могут чередоваться с запорами. Поверхность вокруг ануса краснеет, могут появляться творожистые, слизистые выделения белого цвета. Дети постарше при такой проблеме жалуются на болезненность во время испражнений.
Лечение и профилактика анального кандидоза вызывают множество обсуждений среди пациентов и врачей. Многие отмечают, что своевременное обращение к специалисту помогает избежать осложнений. Важно понимать, что кандидоз может возникнуть не только из-за плохой гигиены, но и на фоне ослабленного иммунитета или длительного приема антибиотиков. Пациенты часто делятся опытом использования противогрибковых препаратов, которые назначает врач, а также народными средствами, такими как отвары трав. Профилактика включает в себя соблюдение личной гигиены, правильное питание и укрепление иммунной системы. Некоторые люди также рекомендуют избегать синтетического белья и тесной одежды, чтобы снизить риск возникновения проблемы. В целом, открытое обсуждение этой темы помогает развеять мифы и повысить осведомленность о важности профилактики и лечения.

Грибок в прямой кишке у беременных женщин
Кандидоз прямой кишки может появиться в период беременности по разным причинам.
К основным провоцирующим факторам можно отнести:
- наличие таких вредных привычек, как курение и употребление алкоголя,
- сопутствующая аллергическая реакция,
- наличие злокачественных образований,
- заболевание аутоиммунного характера,
- длительный прием антибиотиков.
Также следует учитывать, что в период беременности женский организм претерпевает существенные изменения. Иммунная система становится уязвимой и ослабленной, снижаются все защитные функции, меняется работа кишечника и желудка, на матку оказывается повышенное давление.
Клиническая картина проявления грибка заднего прохода в период беременности напоминает собой симптомы токсикоза.
Однако распознать этот недуг можно по следующим признакам:
- дискомфорт и боль в области живота,
- повышенное газообразование,
- жидкий и частый стул,
- наличие в каловых массах творожистых выделений,
- после посещения туалета возникает чувство неполного опорожнения.
При таких жалобах и подтверждении диагноза, лечение должно быть назначено незамедлительно. Иначе женщина рискует столкнуться с определенными осложнениями. Может развиться вагинальная молочница, поражается слизистая оболочка других органов, ребенок внутри утробы может инфицироваться.

Дифференциальная диагностика
Точно поставить диагноз, когда речь идет о грибке заднего прохода, может только врач. Для этого сначала проводится визуальный осмотр. Поэтому женщины посещают гинеколога, а мужчины уролога. После этого назначаются различные анализы, исключающие наличие сопутствующих заболеваний. К ним также относятся анализы на ВИЧ. Обязательно делается соскоб на энтеробиоз. Сдается кал, чтобы определить присутствие либо отсутствие паразитов внутри организма.
Для более быстрой постановки точного диагноза проводятся следующие исследования:
- бактериоскопия кала,
- анализ крови на содержание сахара,
- чувствительность посева испражнений к препаратам противогрибкового назначения,
- фиброколоноскопия,
- сфинктерометрия.
Все эти диагностические мероприятия помогают в кратчайшие сроки определить наличие грибка анального отверстия и тем самым назначить эффективное лечение.
Методы лечения: аптечные средства
При грибке заднего прохода лечение должно быть комплексным. Обычно специалист назначает препараты, к которым будут чувствительны кандиды. Для устранения неприятной симптоматики такого недуга прописываются средства местного использования.
Медикаментозная терапия при таком заболевании основывается на препаратах, действующими веществами которых являются флуконазол, кетоконазол, натамицин, нистатин.
Поэтому наиболее часто специалист назначает следующие лекарства:
- Диафлу и Дифлюкан,
- Фуцис,
- Ливарол и Низорал,
- Орунгал и Ирунин,
- Пимафуцин.
К средствам местного использования, которые обладают антимикотическим воздействием, можно отнести:
- Кандид и Низорал,
- Кандибене и Леварин,
- Клотримазол и Экзодерил.
Пораженную кожную поверхность и слизистые оболочки можно обрабатывать такими антисептическими препаратами, как Мирамистин или Хлоргексидин. Используя лекарственные средства в комплексе, человек не только сможет избавиться от дискомфорта и неприятных ощущений, но и победить патогенный грибок полностью.
Рецепты народной медицины
Ускорить процесс выздоровления и добиться стойкого лечебного результата помогут рецепты народной медицины. Многие из них действительно способны эффективно бороться с грибком, обосновавшимся в области заднего прохода.
Очень полезно делать сидячие ванночки с применением отваров, приготовленных из лекарственных трав и растений:
- цветки ромашки,
- кора дуба,
- листья лопуха,
- цветки зверобоя и календулы.
Чтобы снять сильный зуд и устранить мучающее жжение в области анального отверстия, можно сделать компресс, смоченный в растворе йода и соды. Когда воспалительный процесс переходит в хроническую стадию, поможет компресс на основе меда. Также можно использовать оливковое масло и масло чайного дерева. Эти компоненты, соединенные между собой, прекрасно снимают раздражение пораженной ткани и устраняют все признаки грибковой инфекции.
Помимо вспомогательных мероприятий, направленных на борьбу с таким заболеванием, в период лечения важно правильно организовать свое питание. Для этого лучше отказаться от жирных и жареных, а также острых продуктов. Основной рацион должен состоять из овощей и фруктов, орехов и нежирного мяса, зелени и рыбы, кисломолочных продуктов.
Способы профилактики
Вылечив грибок прямой кишки, необходимо соблюдать рекомендации, которые помогут защититься от повторного возникновения недуга. Нательное белье следует выбирать только из натуральных тканей. Оно не должно быть тесным и узким, чтобы не возникало потертостей кожи и микротравм.
После посещения туалетной комнаты нельзя забывать по соблюдение личной гигиены. Туалетную бумагу лучше использовать мягких сортов. При возникающих трещинах, анальное отверстие можно смазывать обычным детским кремом.
Питание должно быть полноценным. Раз в год следует пропивать комплексы, помогающие укрепить иммунную систему. По возможности нужно избавиться от вредных привычек. Все эти рекомендации помогут больше не беспокоиться о таком заболевании, как грибок анального отверстия.
Вопрос-ответ
Как лечить кандидоз заднего прохода?
Препаратом выбора считается крем клотримазола или препараты резерва: экзодерил и низорал. Эффективными оказываются аппликации противогрибковых средств на фоне повышенных требований гигиены. Принимаются меры к ликвидации энтеробиоза (глистное поражение, вызванное острицами) и лечения анальных трещин.
Какой препарат убивает кандиду в кишечнике?
Для устранения симптомов используют азольные антимикотики («Итраконазол», «Кетоконазол», «Флуконазол»). Они активно всасываются из кишечника и оказывают выраженное системное действие. Терапию обычно начинают с введения «Амфотерицина В», а позже переходят на использование «Флуконазола».
Как убить кандидоз в организме?
Кандидоз лечится противогрибковыми препаратами и в среднем проходит за 2 недели. При подозрении на симптомы кандидоза полости рта можно обратиться к терапевту, стоматологу или гастроэнтерологу, мочеполовой системы — к гинекологу или урологу, а в остальных случаях — к терапевту.
Советы
СОВЕТ №1
Регулярно поддерживайте гигиену интимной зоны. Используйте мягкие, неагрессивные средства для мытья, чтобы избежать раздражения и дисбаланса микрофлоры.
СОВЕТ №2
Обратите внимание на свой рацион. Увеличьте потребление пробиотиков, таких как йогурты и кефир, а также избегайте избыточного потребления сахара, который может способствовать росту грибков.
СОВЕТ №3
При наличии симптомов анального кандидоза, таких как зуд или жжение, не откладывайте визит к врачу. Раннее обращение за медицинской помощью поможет избежать осложнений и ускорить процесс выздоровления.
СОВЕТ №4
Избегайте ношения тесного и синтетического нижнего белья. Предпочитайте хлопковые изделия, которые позволяют коже дышать и уменьшают риск развития грибковых инфекций.



